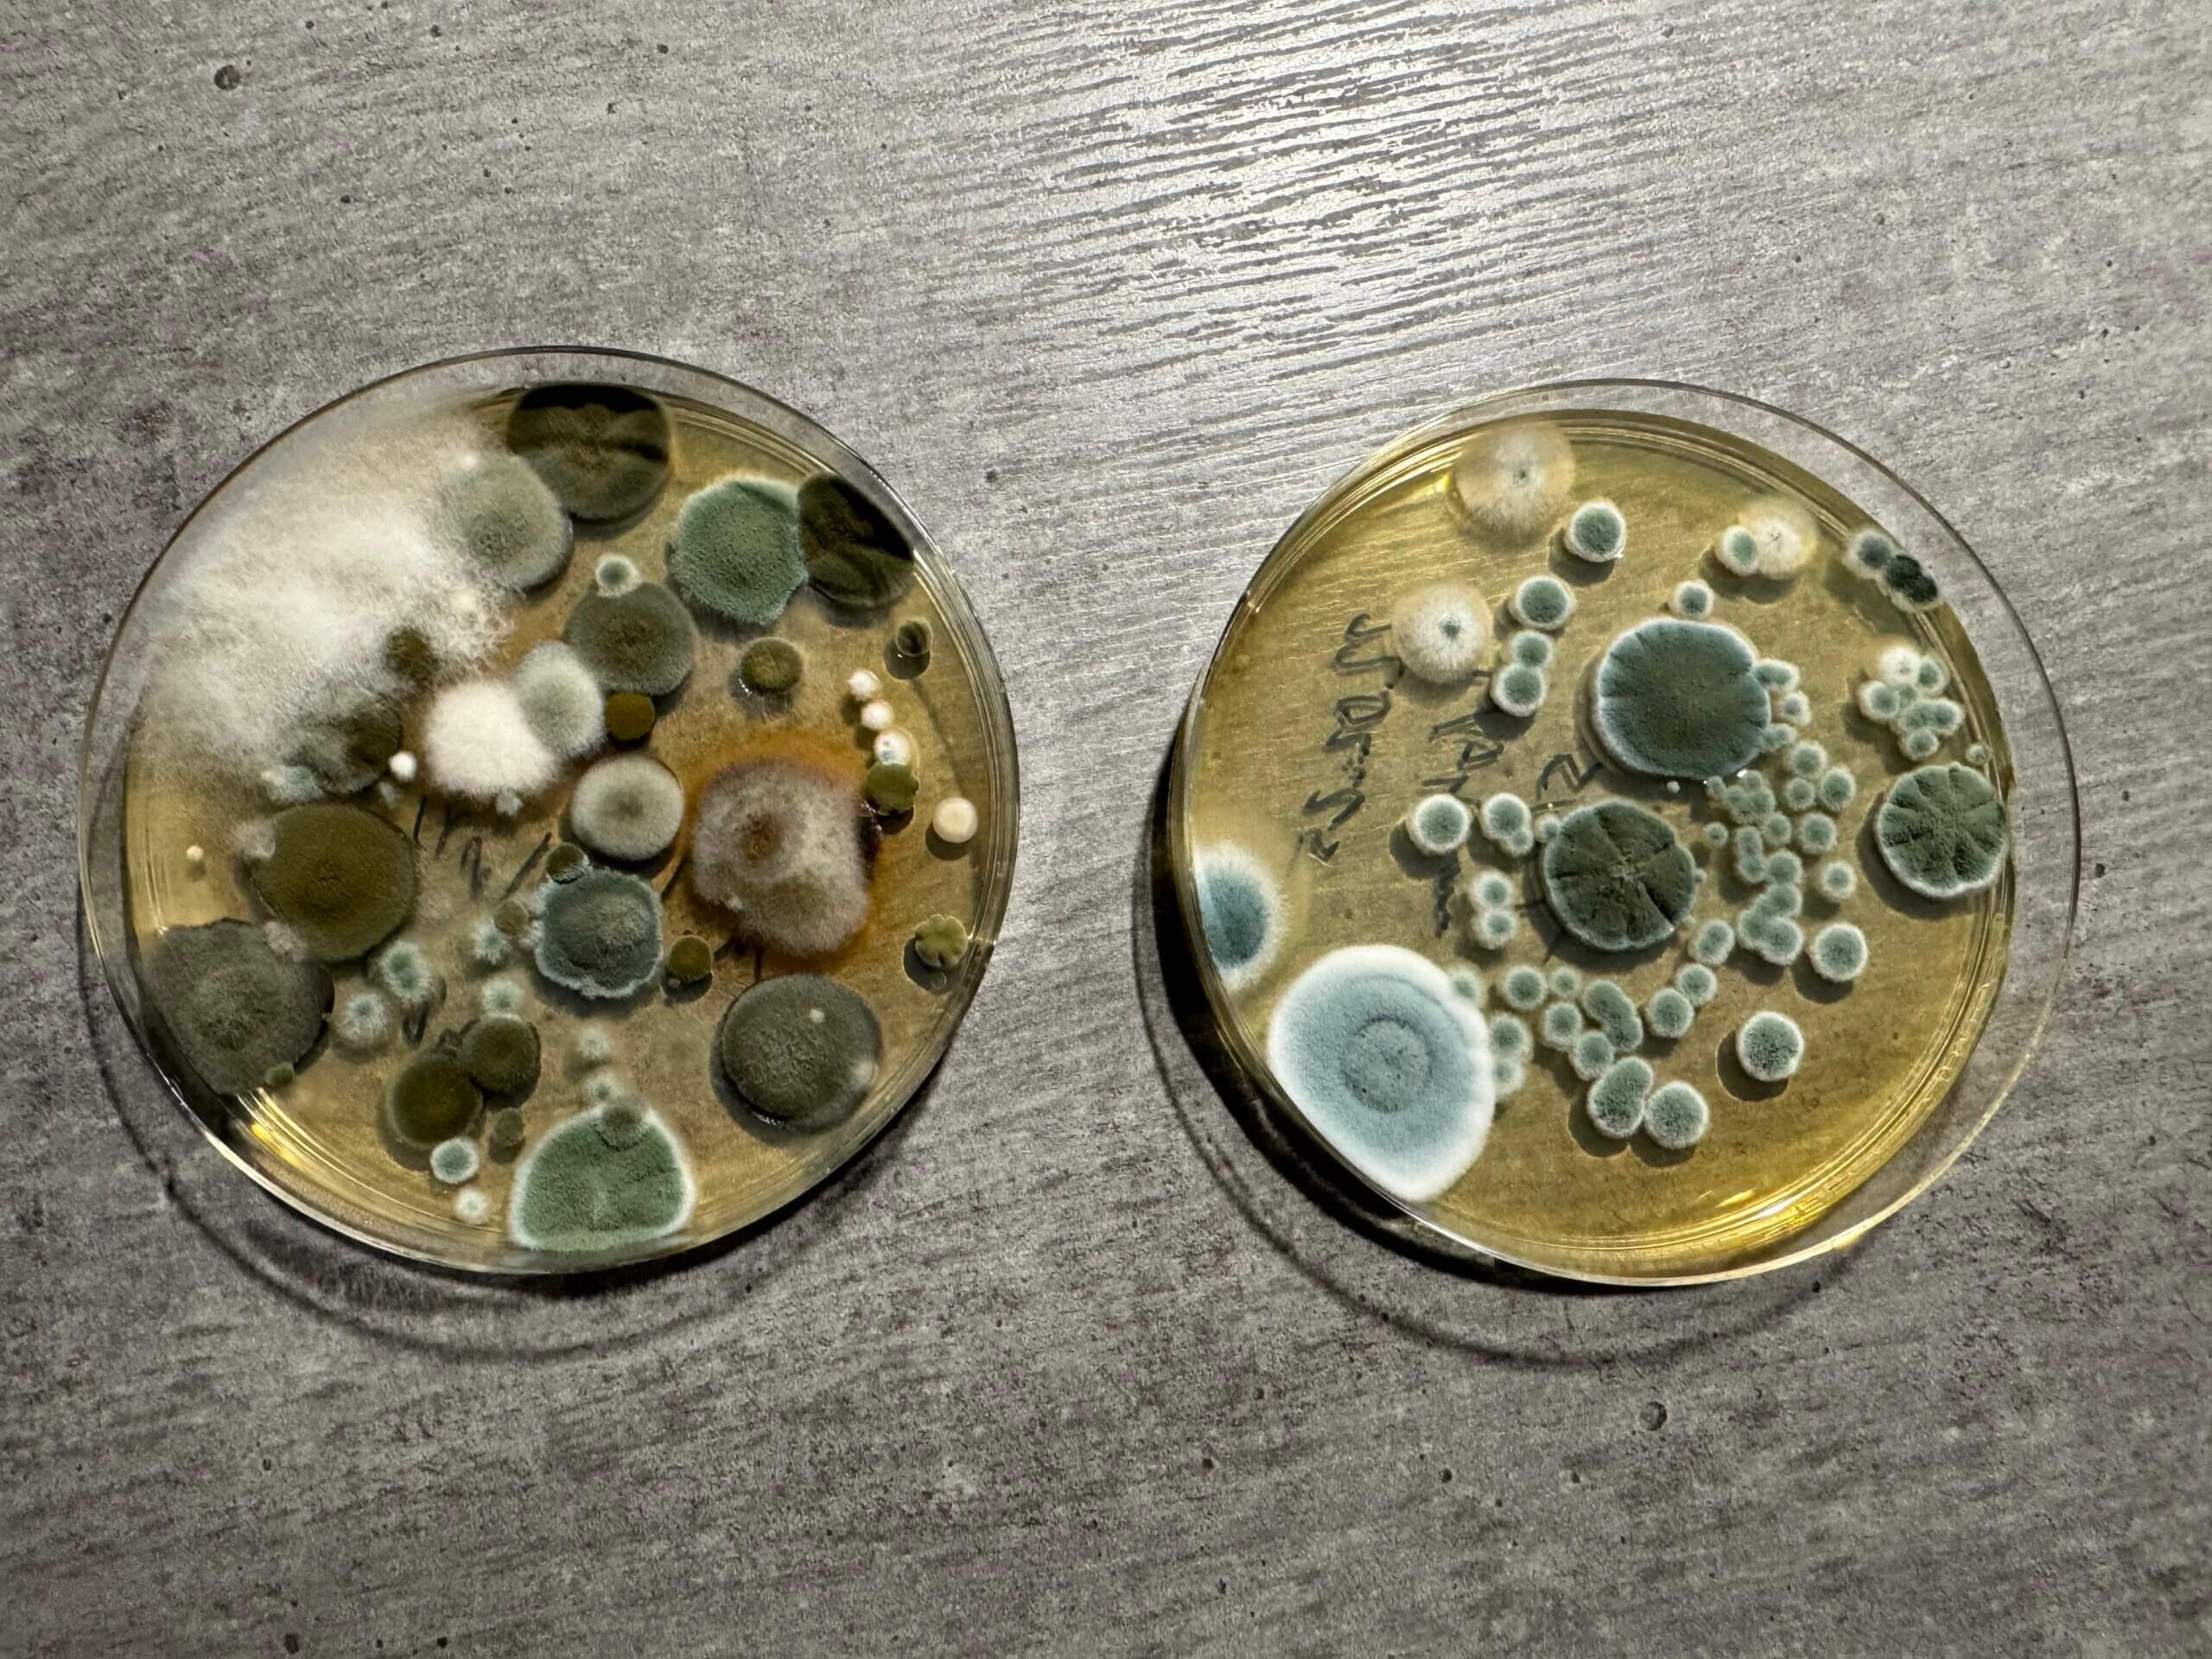

Die Luftkeimsammlung wird beispielsweise nach einer Schimmelpilzsanierung angewendet, um eine erfolgreiche Durchführung nachzuweisen zu können, die sogenannte „Freimessung“.
Mit diesem Verfahren können jedoch auch die Art sichtbarer Schimmelpilze bestimmt werden bzw. bei einem vermuteten, nicht sichtbaren Schimmelbefall, der Nachweis eines vorhandenen Befalls nachgewiesen werden.
Hierbei wird ein vorab bestimmtes Volumen der Raumluft angesaugt und die in der Luft vorhandenen Sporen auf in das Gerät eingesetzte Nährböden geleitet. Im Labor werden diese Nährböden dann kultiviert und die koloniebildenden Einheiten (KBE) pro m³ Luft dokumentiert. Dies führt dann im Vergleich zu einer parallel genommenen Probe der Außenluft zu einem aussagefähigen Ergebnis.
Es sind hierfür spezielle Geräte und Nährböden erforderlich.

Bei Fäkalwasserschäden wird dieses Verfahren durch mich nicht angewendet, da es hier zu verfälschten Ergebnissen kommen kann, auch wenn hierfür spezielle Nährböden erhältlich sind. Der Grund hierfür liegt in der starken Austrocknungsempfindlichkeit von E. coli und vielen coliformen Bakterien.
[Quelle: VDB-Leitfaden zur Beurteilung und Sanierung von Fäkalschäden in Gebäuden]
Hierfür eignen sich Materialproben besser.
Gerne können Sie durch mich die Luftkeimsammlung bei Schimmelsporen oder eine Materialprobe bei Fäkalschäden erbringen lassen. Sie erhalten damit einen aussagefähigen Bericht von einem spezialisierten Fachlabor und natürlich eine Beurteilung zur weiteren Vorgehensweise.
Ausführliche Informationen zum VDB Leitfaden zur Beurteilung und Sanierung von Fäkalschäden finden Sie unter folgendem Link:
https://baubiologie.net/media/faekalleitfaden_gelbdruck_220620_02.pdf